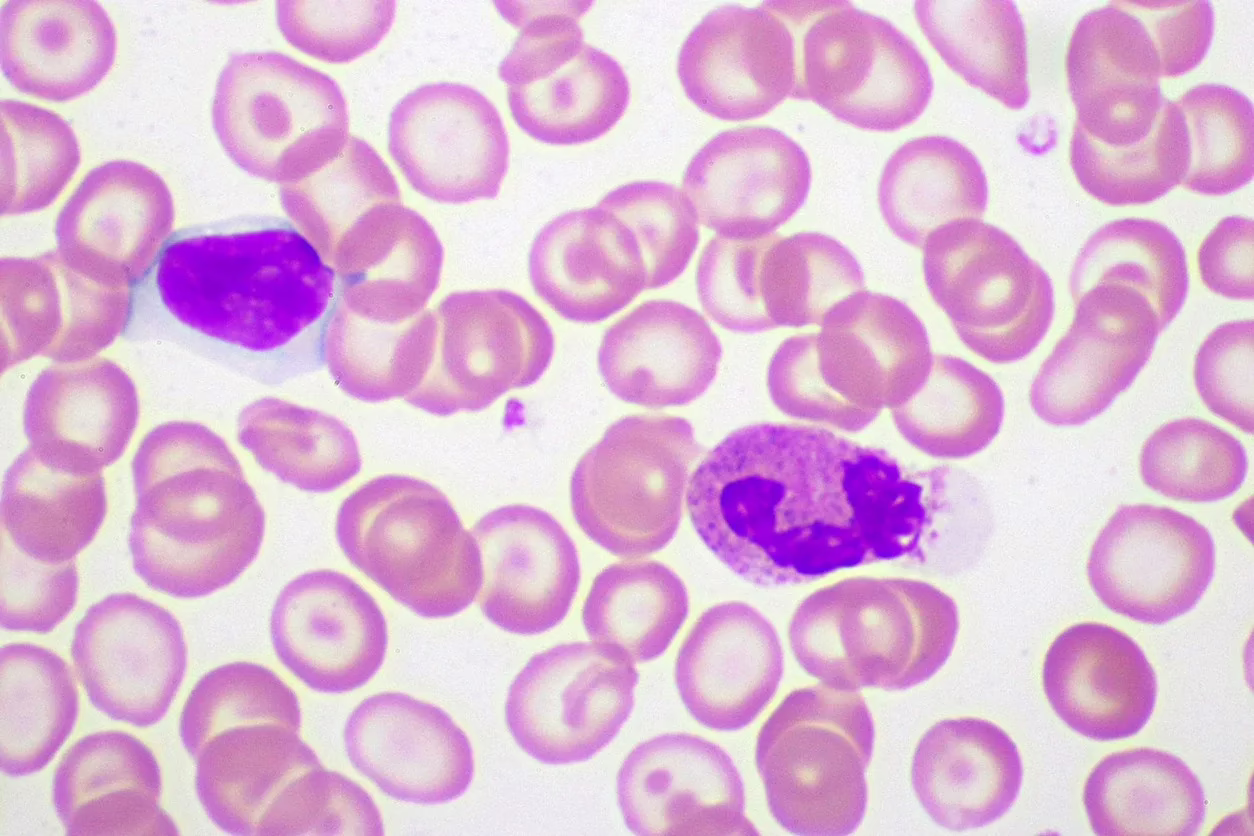

KPV Peptide and Inflammation
It may be suggested that KPV exhibits a pronounced anti-inflammatory effect, particularly in the small intestines, where it has been under investigation for its potential relevance in inflammatory bowel disease (IBD) research. Beyond the small intestine, researchers suggest that KPV peptide may exhibit potent anti-inflammatory effects in the central nervous system, vascular system, gastrointestinal tract, and lungs.
Research suggests that KPV may produce potential anti-inflammatory action through various mechanisms. It is speculated that KPV may potentially inactivate inflammatory pathways within cells by directly interacting with inflammatory signaling molecules that mediate the inflammatory response. It may enter the nucleus, hypothetically inactivating and halting inflammatory processes.
Speculative research proposes that this mechanism may be how it exerts a potential anti-inflammatory effect in the gut. There are suggestions that KPV might also halt pro-inflammatory mechanisms in intestinal epithelial cells and immune cells. Moreover, KPV may interact directly with immune cells, reducing inflammation. Research findings report that KPV significantly reduced inflammation in colitis, allegedly inhibiting the synthesis and secretion of pro-inflammatory cytokines, which are considered to assist in cases of IBD through inhibited immune responses.
KPV Peptide and Anti-microbial Action
Preliminary findings from research suggest that, in addition to potential anti-inflammatory effects, KPV peptide may exhibit certain antimicrobial characteristics as well. The antimicrobial activity may be targeted against two specific microbes, namely Staphylococcus Aureus and Candida Albicans. Studies suggest that KPV may inhibit the growth of S. aureus colonies.
Wound Healing and Skin Cells
Research in progress suggests that KPV peptide may potentially accelerate wound healing through speculative reductions in infection (antimicrobial) and the potential combatting of inflammation (anti-inflammatory). Research is ongoing.
Disclaimer: The products mentioned are not intended for human or animal consumption. Research chemicals are intended solely for laboratory experimentation and/or in-vitro testing. Bodily introduction of any sort is strictly prohibited by law. All purchases are limited to licensed researchers and/or qualified professionals. All information shared in this article is for educational purposes only.